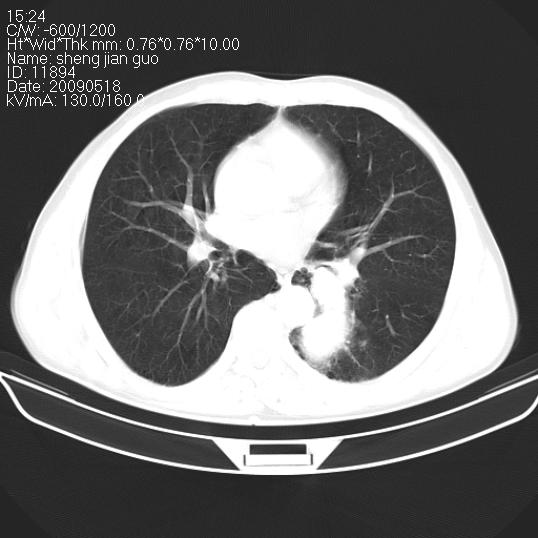
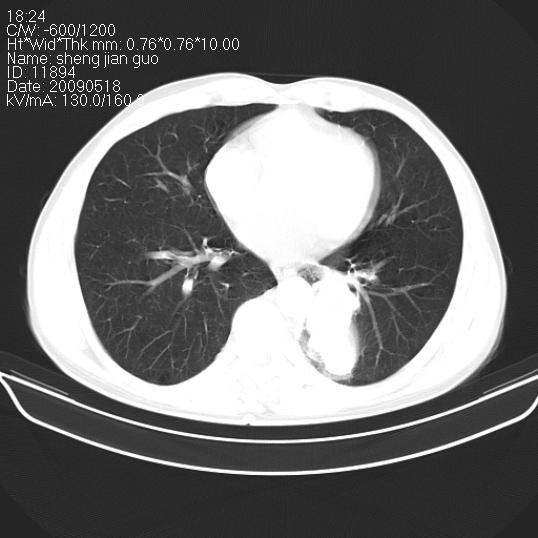
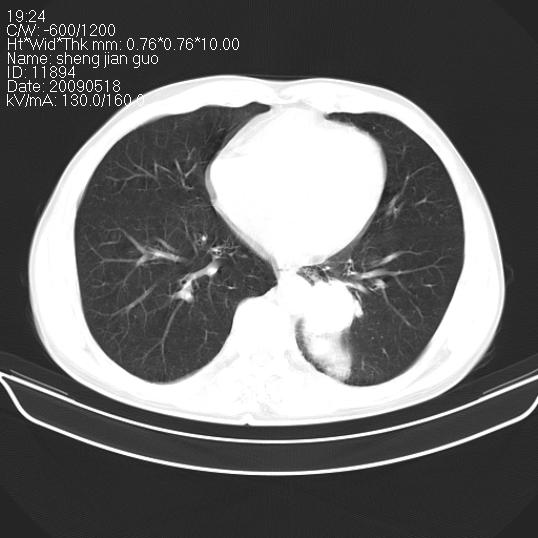
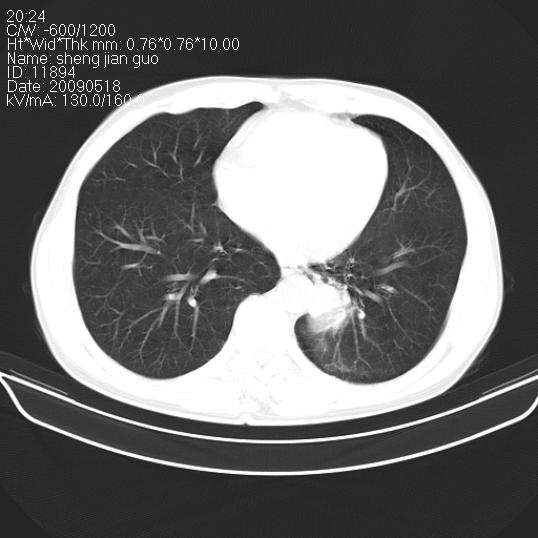

以下是引用zjzjr在2009-5-19 17:25:00的发言:[br]支持楼主考虑,另左肺下叶阻塞性炎症。
以下是引用zhao_bin2008在2009-5-19 17:48:00的发言:[br]支持左肺下叶周围型肺癌并阻塞性肺炎。
以下是引用杀毒软件在2009-5-19 17:36:00的发言:[br]支持楼主
以下是引用zsl6918在2009-5-20 7:10:00的发言:[br]左侧中心型肺癌!
| 欢迎光临 医影在线 (http://bbs.radida.com/bbs/) | Powered by Discuz! X3.2 |